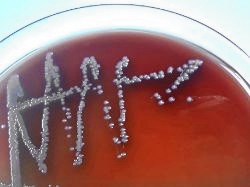

| Raoultella terrigena colonies on Sheep Blood Agar |
| Raoultella terrigena |
Taxonomy
Morphology
Cultural characteristics
Biochemical characters
Ecology
Pathogenicity
References
Phylum Pseudomonadota (Proteobacteria), Class Gammaproteobacteria, Order Enterobacterales, Family Enterobacteriaceae, Genus
Raoultella, Raoultella terrigena (Izard et al. 1981) Drancourt et al. 2001.
Basonym: Klebsiella terrigena Izard et al. 1981.
Raoultella, Raoultella terrigena (Izard et al. 1981) Drancourt et al. 2001.
Basonym: Klebsiella terrigena Izard et al. 1981.
Gram-negative, straight rods, 0.3-1.0 μm x 0.6-6 μm. Non-motile. Capsulated.
Glistening moist colonies of varying degrees of stikiness (M–type colonies).
No special requirements. Facultatively anaerobic, optimum growth temperature 35 -
37 ºC. Can grow at 5 ºC, but not at 41 ºC. Media: Nutrient agar or Nutrient broth,
Trypticase Soy Agar ± 5% sheep blood, Mac Conkey agar, Mueller-Hinton agar.
No special requirements. Facultatively anaerobic, optimum growth temperature 35 -
37 ºC. Can grow at 5 ºC, but not at 41 ºC. Media: Nutrient agar or Nutrient broth,
Trypticase Soy Agar ± 5% sheep blood, Mac Conkey agar, Mueller-Hinton agar.
Widely distributed in nature. Isolated mainly from aquatic and soil environments,
some from clinical specimens (humans and animals).
Isolated from human mouth (admin note).
some from clinical specimens (humans and animals).
Isolated from human mouth (admin note).
Undetermined.
- J. G. Holt et al., 1994. Facultatively Anaerobic Gram-Negative Rods. Subgroup 1. Family Enterobacteriaceae. In: Begey’s Manual of
Determinative Bacteriology, 9th-edition, Williams & Wilkins, pp 175-189. - Don J. Brenner and J.J. Farmer III, 2001. Family I. Enterobacteriaceae. In: Bergey’s Manual of Systematic Bacteriology, Second
edition, Vol two, part B, George M. Garrity (Editor-in-Chief), pp 587-897. - M. Drancourt, C. Bollet, A. Carta, and P. Rousselier. Phylogenetic analyses of Klebsiella species delineate Klebsiella and
Raoultella gen. nov., with description of Raoultella ornithinolytica comb. nov., Raoultella terrigena comb. nov. and Raoultella
planticola comb. nov. Int J Syst Evol Microbiol May 2001 51:925-32. - Adeolu M, Alnajar S, Naushad S, S Gupta R. Genome-based phylogeny and taxonomy of the 'Enterobacteriales': proposal for
Enterobacterales ord. nov. divided into the families Enterobacteriaceae, Erwiniaceae fam. nov., Pectobacteriaceae fam. nov.,
Yersiniaceae fam. nov., Hafniaceae fam. nov., Morganellaceae fam. nov., and Budviciaceae fam. nov. Int J Syst Evol Microbiol
2016; 66:5575-5599.
Positive results for ONPG, lysine decarboxylase, catalase, nitrate reduction, esculin
hydrolysis (most strains), acid production from: L-arabinose, D-adonitol, cellobiose,
glucose, mannitol, melibiose, maltose, D-mannose, raffinose, salicin, trehalose and
D-xylose.
Negative results for oxidase, arginine dihydrolase, H2S production, phenylalanine
deaminase, gelatin hydrolysis, DN-ase and lipase.
Variable results for methyl red test, acetate utilization, acid production from dulcitol
and inositol.
hydrolysis (most strains), acid production from: L-arabinose, D-adonitol, cellobiose,
glucose, mannitol, melibiose, maltose, D-mannose, raffinose, salicin, trehalose and
D-xylose.
Negative results for oxidase, arginine dihydrolase, H2S production, phenylalanine
deaminase, gelatin hydrolysis, DN-ase and lipase.
Variable results for methyl red test, acetate utilization, acid production from dulcitol
and inositol.

(c) Costin Stoica

| Antibiogram |
| Encyclopedia |
| Culture media |
| Biochemical tests |
| Stainings |
| Images |
| Movies |
| Articles |
| Identification |
| Software |
| R E G N U M PROKARYOTAE |
Differential characters of the Raoultella species:
Legend: + positive 90-100%, - negative 90-100%, [+] positive 75-89%, [-] negative 75-89%,
d positive 25-74% of strains
d positive 25-74% of strains
| Raoultella terrigena Gram-negative rods |
|